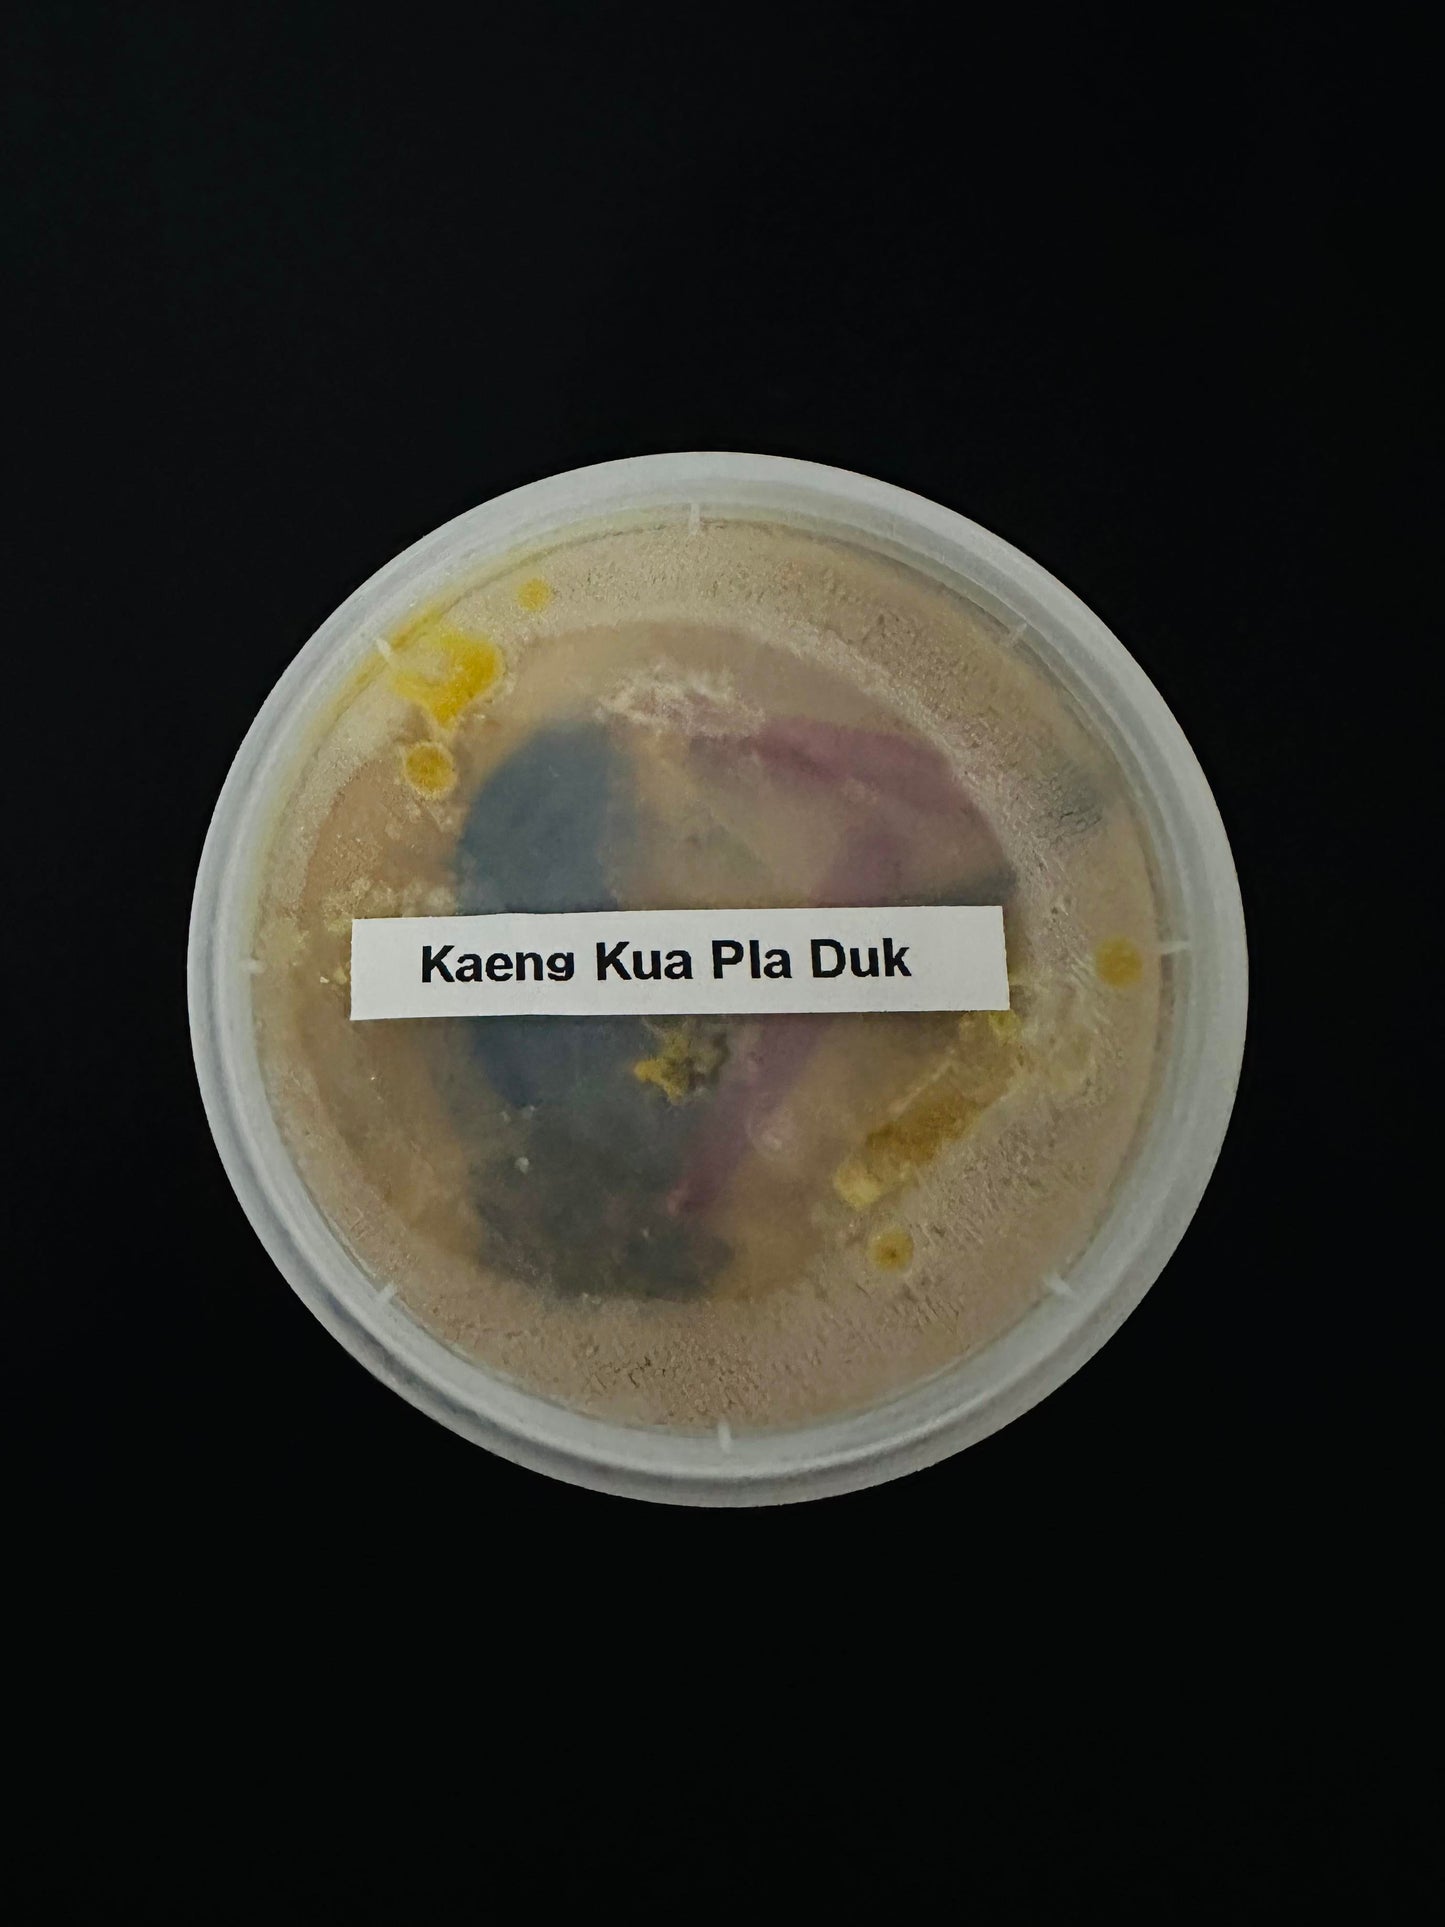

Roynee
Cat fish Kaeng Kua (Pla Duk) 🌶️🌶️🌶️🌶️
Cat fish Kaeng Kua (Pla Duk) 🌶️🌶️🌶️🌶️
Impossible de charger la disponibilité du service de retrait
Kaeng Kua Pla Duk - Southern Thailand
A delectable Thai dish that features Pla Duk, which is catfish, in a rich and flavorful curry. This dish is known for its bold and aromatic blend of herbs, spices, and curry paste. The catfish is simmered in the fragrant curry, absorbing the flavors and resulting in tender and succulent fish. The curry itself is typically spiced with ingredients like galangal, lemongrass, chili, and kaffir lime leaves, creating a harmonious balance of heat, tanginess, and umami.
Kaeng Kua Pla Duk is a popular Thai specialty that showcases the intricate and vibrant flavors of Thai cuisine.
Recommendation: Serve with a portion of hot steamed jasmin rice.
Falang Spicy level: 4/4
Thai spicy level: 2/4
Format: Frozen, 500ml, rice not included!
*Thanya's favourite dish* and she would put a fried egg on top with a side of fresh cucumbers.